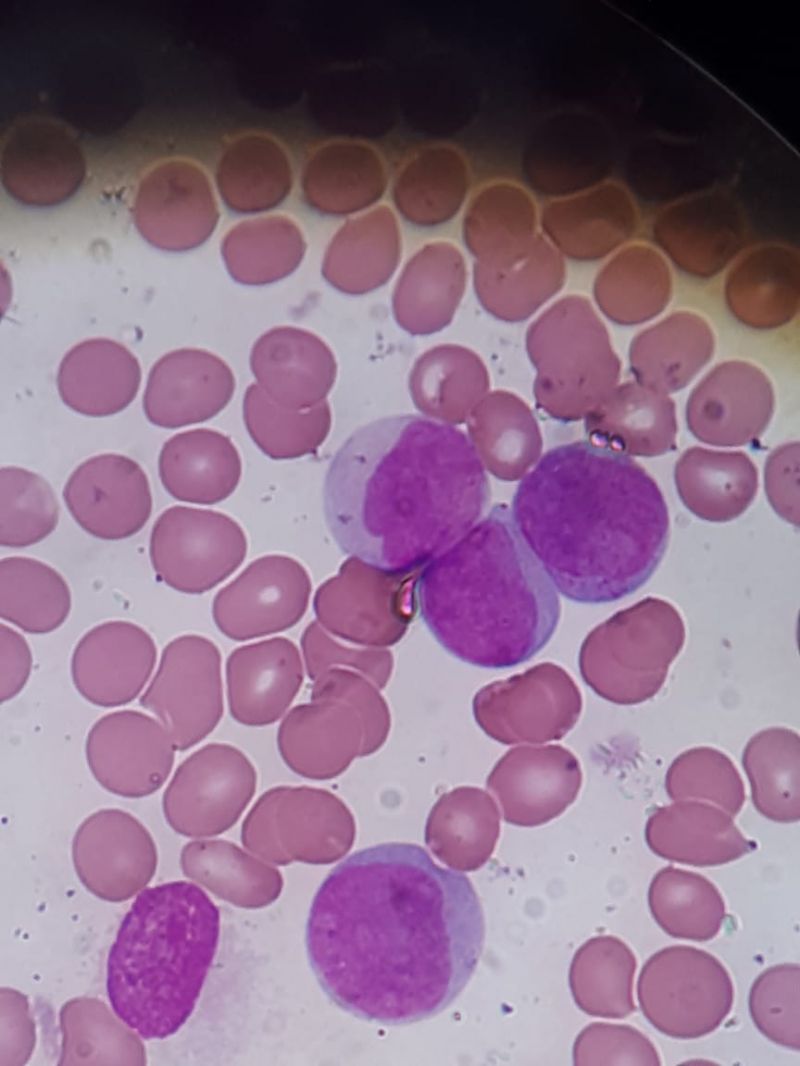
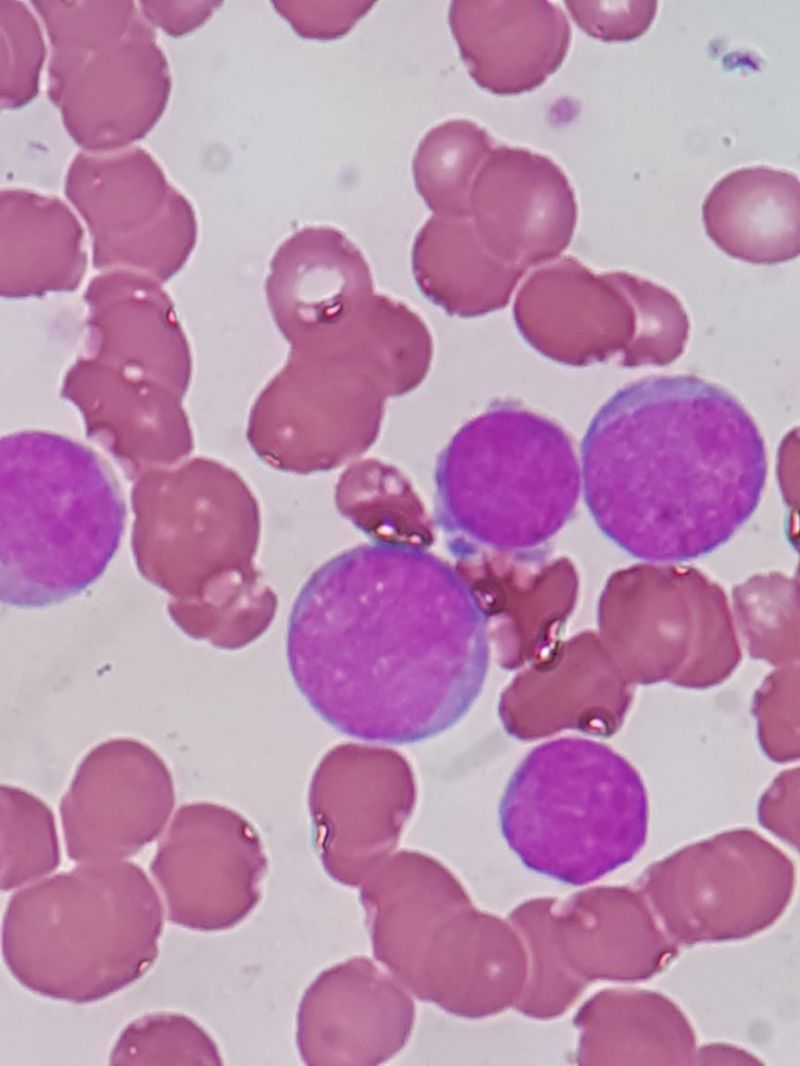

Leucemia Mieloide Aguda M2 Caso Clinico
#Leucemia #Sindromes #exames #HemoClass Leucemias

Leucemia Mielóide Aguda M2 (FAB) ou Leucemia Mielóide Aguda com translocação 8:21 (OMS)
Apresentação de Caso e Revisão Literária
Paciente com 64 anos, procura o médico com queixas de falta de apetite, cansaço e fraqueza.
Hemograma:
Eri: 3,23 / Hb: 9,2 / VG: 26 / VCM: 83 / HCM: 29,4 / CHCM: 35,4 / RDW: 13,5
Leucócitos totais: 67,4
Dif. Aparelho:
Linf. 33,7 / Mon. 27 / Gran: 39,3
Plaquetas: 81.000
Percebe-se claramente a tríade leucêmica ao analisar o hemograma. Os blastos não apresentam bastonetes de auer, entretanto mostram inclusões que lembram os corpos de PHI.
Pelas fotos percebe-se claramente a presença de blastos, e a contagem diferencial foi:
Blastos: 83% / Prómielócitos: 2% / segmentados: 2% / linfócitos: 12% / monócitos: 1%
As observações incluíram:
Blastos de tamanho pequeno à médio, com moderada relação N/C, crimatina frouxa e nucléolos evidentes, alguns com citoplasma granular e núcleos pleomórficos.
Após encaminhamento ao hematologista, o mielograma foi realizado:
O mielograma revelou uma medula óssea hipercelular, infiltrada por 68% de mieloblastos, com maturação granulocítica, representada por 16% de granulócitos parcialmente hipogranulares. Celularidade restante com 8% de eritroblastos, 2% de linfócitos e 6% de monócitos. Hipoplasia granulocítica, e ausência de parasitos e células estranhas à medula.
Os critérios diagnósticos descritos na literatura para LMA m2 são:
- Blastos > que 30% das células da MO
- Blastos entre 30 e 89% das células não eritróides da MO
- Componente granulocítico em maturação > 10% das células não eritróides
- Componente monocítico (monoblasto para monócito) <20% das céluas não-eritróides.
- Ausência de critérios da m4
Com essa descrição a sugestividade diagnóstica ficou para LMA m2, devendo ser feita a imunofenotipagem para confirmação.
Revisão da LMA m2:
O mieloblasto se apresenta, na maioria das vezes dos casos de LMA m2, com uma cromatina porosa, um ou dois nucléolos, relação N/C diminuída e grânulos citoplasmáticos.
Geralmente os Bastonetes de auer são frequentes, o que não se observou nesse caso. Promielócitos, mielócitos e granulócitos maduros com variados graus de displasia são vistos na medula óssea, conforme o descrito no mielograma.
Os eritroblastos e megacariócitos são morfologicamente normais. A reação citoquímica para MPO é positiva em pelo menos 3% dos blastos, quando realizada.
Essa leucemia corresponde a 12% de todos os casos de LMA, sendo mais comum em crianças e adultos jovens. Ainda é comum se achar pseudo-chediak-higashi em uma variante da m2, e hipogranulia nos neutrófilos, conforme relatado.
Na imunofenotipagem os blastos apresentam os marcadores: MPO, CD13, CD33, CDw65, CD117, e a alteração genética característica é a translocação 8:21 (q22;q22)
Relevância clínica: A LMA-M2 t(8;21) tem maior taxa de remissão completa e possui melhor prognóstico em pacientes adultos; em crianças os estudos ainda são inconclusivos.
Existe uma variante da m2, que apresenta as seguintes características:
Blastos grandes, com frequente bastonete de auer e granulação abundante
- Comum granulócitos imaturos com displasia (PM, MI, MT)
- Pode aparecer pseudo-Pelger-Huet e Pseudo-Chediak-Higashi
- Pode aparecer precursores eosinofílicos na MO e não em SP
- Comum em pacientes com síndrome de Down
- Marcadores extras: CD19 e CD56
Gostou do nosso conteúdo?
Cadastre-se para receber nossos conteúdos exclusivos.